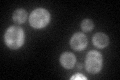
YDL040C
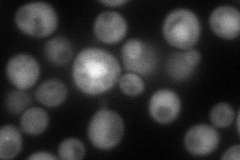
YDL040C
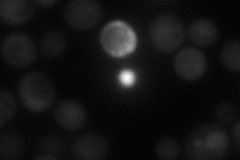
YDL040C
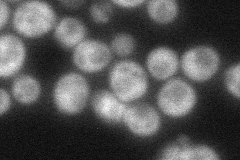
YDL040C
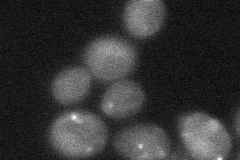
YDL040C
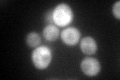
YDL040C
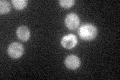
YDL040C

View description
Subunit of the N-terminal acetyltransferase NatA (Nat1p, Ard1p, Nat5p); N-terminally acetylates many proteins, which influences multiple processes such as the cell cycle, heat-shock resistance, mating, sporulation, and telomeric silencing
Localization:
Intensity:
Fold change:
Significance:
-
C’ GFP library in SD
cytosol49.96 -
N' NOP1pr-GFP in SD
cytosol,nucleus94.4457 -
N' TEF2pr-mCherry in SD
cytosol43.8094 -
N' NATIVEpr-GFP in SD
cytosol62.2982 -
N' TEF2pr-VC and Cyto-VN in SD
cytosol32.3151 -
C’ GFP library in SD+DTT
cytosol56.81.13No -
C’ GFP library in SD+H2O2

cytosol58.11.16No -
C’ GFP library in Starvation Media
cytosol35.040.7No -
C’ GFP library on the background of Pup2-DaMP

N/A -
C’ GFP library on the background of CCT mutant

N/A0N/AYes
